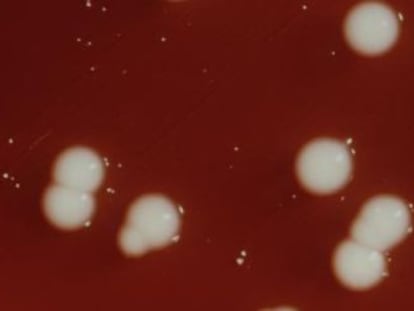

Médicos peruanos abandonan un hospital tras 23 días de huelga
Los gremios reclaman el cumplimiento de acta firmada por el Gobierno en octubre En lo que va del año han muerto 44 personas por la influenza AH1N1 y se incrementa el contagio

Los gremios reclaman el cumplimiento de acta firmada por el Gobierno en octubre En lo que va del año han muerto 44 personas por la influenza AH1N1 y se incrementa el contagio
Los alcaldes de las localidades con menos recursos presentan 15.000 solicitudes
El anteproyecto limita la colegiación obligatoria a profesiones sanitarias, jurídicas y a las técnicas que exijan visado
Los médicos prohibieron a una colega que atendiera a la mujer pese a que la póliza incluía los servicios de la facultativa

El tribunal rechaza la petición de la viuda de Tony Nicklinson, que falleció en agosto de 2012 en plena batalla legal por el derecho al suicidio asistido

Resucitan ahora el compromiso de una asistencia sanitaria “pública, gratuita y universal" El portavoz del PSOE en el Congreso critica al Gobierno por dejar fuera a las comunidades

El TSJ valenciano tumbó la semana pasada un programa de despido masivo similar
Compromís hace pública la retribución del equipo directivo, que dice que la cifra es incorrecta

Médicos y enfermeros prolongaron su turno para atender a los heridos del accidente de Santiago "Nada te prepara para algo así", relata la coordinadora de urgencias del centro sanitario

Las centrales abogan por la negociación directa con la Generalitat Salud considera que la propuesta de los sindicatos no es realizable
En España se pasó de unos "brotes esporádicos hospitalarios" a una "difusión regional" Los pacientes infectados demandan una mayor inversión de los recursos sanitarios Una de las desventajas de los médicos es que se ha detenido la innovación en antibióticos

El colegio de Alicante aclara que los facultativos retirados podrán seguir en la privada
No se prevé ningún concurso de méritos para su sustitución, será por designación digital

La red social Neomed crea una aplicación para España, que ha tenido éxito en EE UU Por pregunta, los galenos obtienen como promedio cinco respuestas en menos de 48 horas
La campaña pretende captar a 7.000 médicos en España de atención primaria. El Gobierno brasileño pretende asistir a municipios rurales y de la periferia del país.

Los estudiantes deberán trabajar dos años en la atención pública para licenciarse, lo que el gremio ve como "trabajo esclavo"
La Generalitat prepara un protocolo para promover que los médicos de atención primaria detecten mejor a las personas en riesgo
Vicente Ferrer vino a abrir pozos de agua a la tierra más olvidada y se convirtió en un zahorí de la esperanza

El despido del único médico y un fisioterapeuta empujan al equipo nacional a pedir soluciones al CSD

Un informe de este organismo señala que solo en otros tres países ha caído el gasto dos años
El juzgado cita a los facultativos al reabrir el caso de una mujer que dio a luz en 1965 Es el segundo caso que se reabre en Valencia por la presunta sustracción de niños

La Sociedad de Sanidad Penitenciaria denuncia que Interior solo administra en un 10% de casos un medicamento para la ansiedad que cuesta un euro al día

A partir de ahora los médicos se comprometerán más con una afección que padece casi un tercio de la población

El juzgado protege al médico, citado a declarar como imputado por detención ilegal El ginecólogo asegura no conocer a la mujer a la que entregó a la niña en 1969
Tres técnicos de ambulancias declaran como testigos ante el juez

El Colegio de Médicos de Madrid considera que la doctora Baena no cometió ninguna infracción El órgano no se pronuncia sobre el estado de salud del secuestrador cuando fue liberado
El proyecto de ley estipula que los 25 establecimientos autorizados estarán obligados a realizar esa intervención

El médico declara que la enfermería contaba con el instrumental "adecuado" Es la primera vez que se escucha su versión, tras 'plantar' a la comisión del Ayuntamiento

Los médicos jóvenes se enfrentan a las mayores tasas de paro Se debaten entre reciclarse y repetir el MIR o hacer la maleta Formarles cuesta hasta 200.000 euros

Médicos en desempleo Solicitudes del certificado de idoneidad Principales países de destino de los médicos españoles
Ser médico en la Clínica Mayo es lo más parecido al sueño que todos tuvimos el día en que decidimos dedicarnos a esto

El encarcelamiento de Alan Gross es el principal obstáculo para restaurar la relación bilateral entre ambos países

La asociación Afem asegura que los pliegos tienen defectos y son "absolutamente ilegales" "Privatizan la Seguridad Social" como si fuera un sistema de mutuas, denuncian
Nos encontramos con un panorama preocupante en el que una profesión antes atractiva ofrece ahora pocas expectativas

Abderramán B. se enfrenta a 28 años de cárcel por agredir con un hacha a tres sanitarias El suceso ocurrió en un centro de salud de Fuenlabrada en 2011
Los presidentes de los colegios profesionales debatirán sobre las expectativas del sector

Una ginecóloga explica ante el juez el protocolo especial para los niños que se quedaba la monja Un doctor asegura que dos supuestas gemelas robadas murieron por prematuras
El 16% culpa a las autoridades de que haya espacios cerrados donde aún se fume